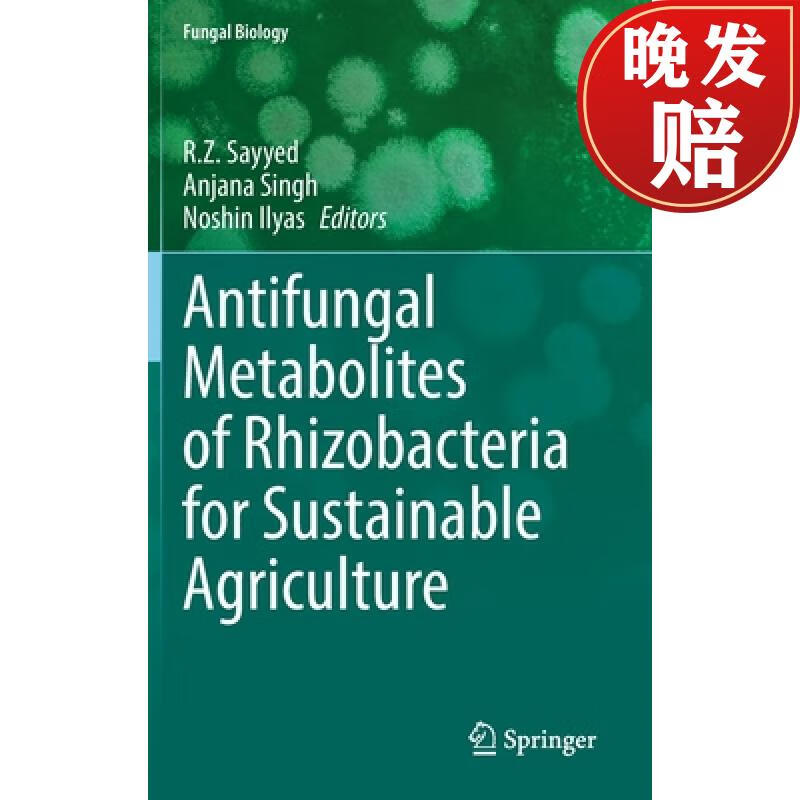
【4周达】antifungal metabolites of rhizobacteria for sustainable

antifungal

40a antifungal drugs
图片尺寸1080x810
antifungal antibacterial soap & body wash - natural f
图片尺寸880x573
amazon.com: lotrimin af antifungal cream for athlete s foot, .
图片尺寸459x400
苏州现货lotrimin af jock itch antifungal powder spray当天发
图片尺寸1280x1280
韩国脚气膏15g losinol antifungal agent
图片尺寸1080x1440
【4周达】antifungal metabolites of rhizobacteria for sustainable
图片尺寸800x800
【预售 按需印刷】application for the antifungal protein from
图片尺寸907x1360
预订antifungal potentials of medicinal plants
图片尺寸267x400
【按需印刷】antifungal therapy, second edition
图片尺寸800x800
【预售】antifungal therapy, second edition
图片尺寸353x499
预订 antifungal compounds discovery
图片尺寸266x400
【4周达】antifungal plant growth
图片尺寸800x800
海外直订screening antifungal potential of indian spices and
图片尺寸800x800
预订 antifungal agents
图片尺寸285x400
antifungal tea tree oil body wash - made in usa - helps t
图片尺寸880x573
海外直订antifungal-screening and eco-friendly botanical
图片尺寸800x800
【4周达】antifungal drugs methods
图片尺寸800x800![[预订]antifungal immunity](https://imgs.wantubizhi.com/img/31326CE759A4D648D73F1BAC447D16C0B223F5B006627671FFA58941C56CF825D9A7DEABABBF71AD0C6D64EC2FD124625A3B6636101A0AC64D14A2CF0E7056C9067DFD406A74364F17ABA24A36B4FA9025818F455EF564F6FDDE4A4E236553F8)
[预订]antifungal immunity
图片尺寸283x400
【预订】antifungal agents 9781617374678
图片尺寸500x500
【预售】antifungal therapy
图片尺寸243x346














![[预订]antifungal immunity](https://imgs.wantubizhi.com/img/31326CE759A4D648D73F1BAC447D16C0B223F5B006627671FFA58941C56CF825D9A7DEABABBF71AD0C6D64EC2FD124625A3B6636101A0AC64D14A2CF0E7056C9067DFD406A74364F17ABA24A36B4FA9025818F455EF564F6FDDE4A4E236553F8)

![[预订]antifungal immunity](https://img.alicdn.com/bao/uploaded/i3/454266620/O1CN011zysdP1ym0myHr344_!!0-item_pic.jpg)

